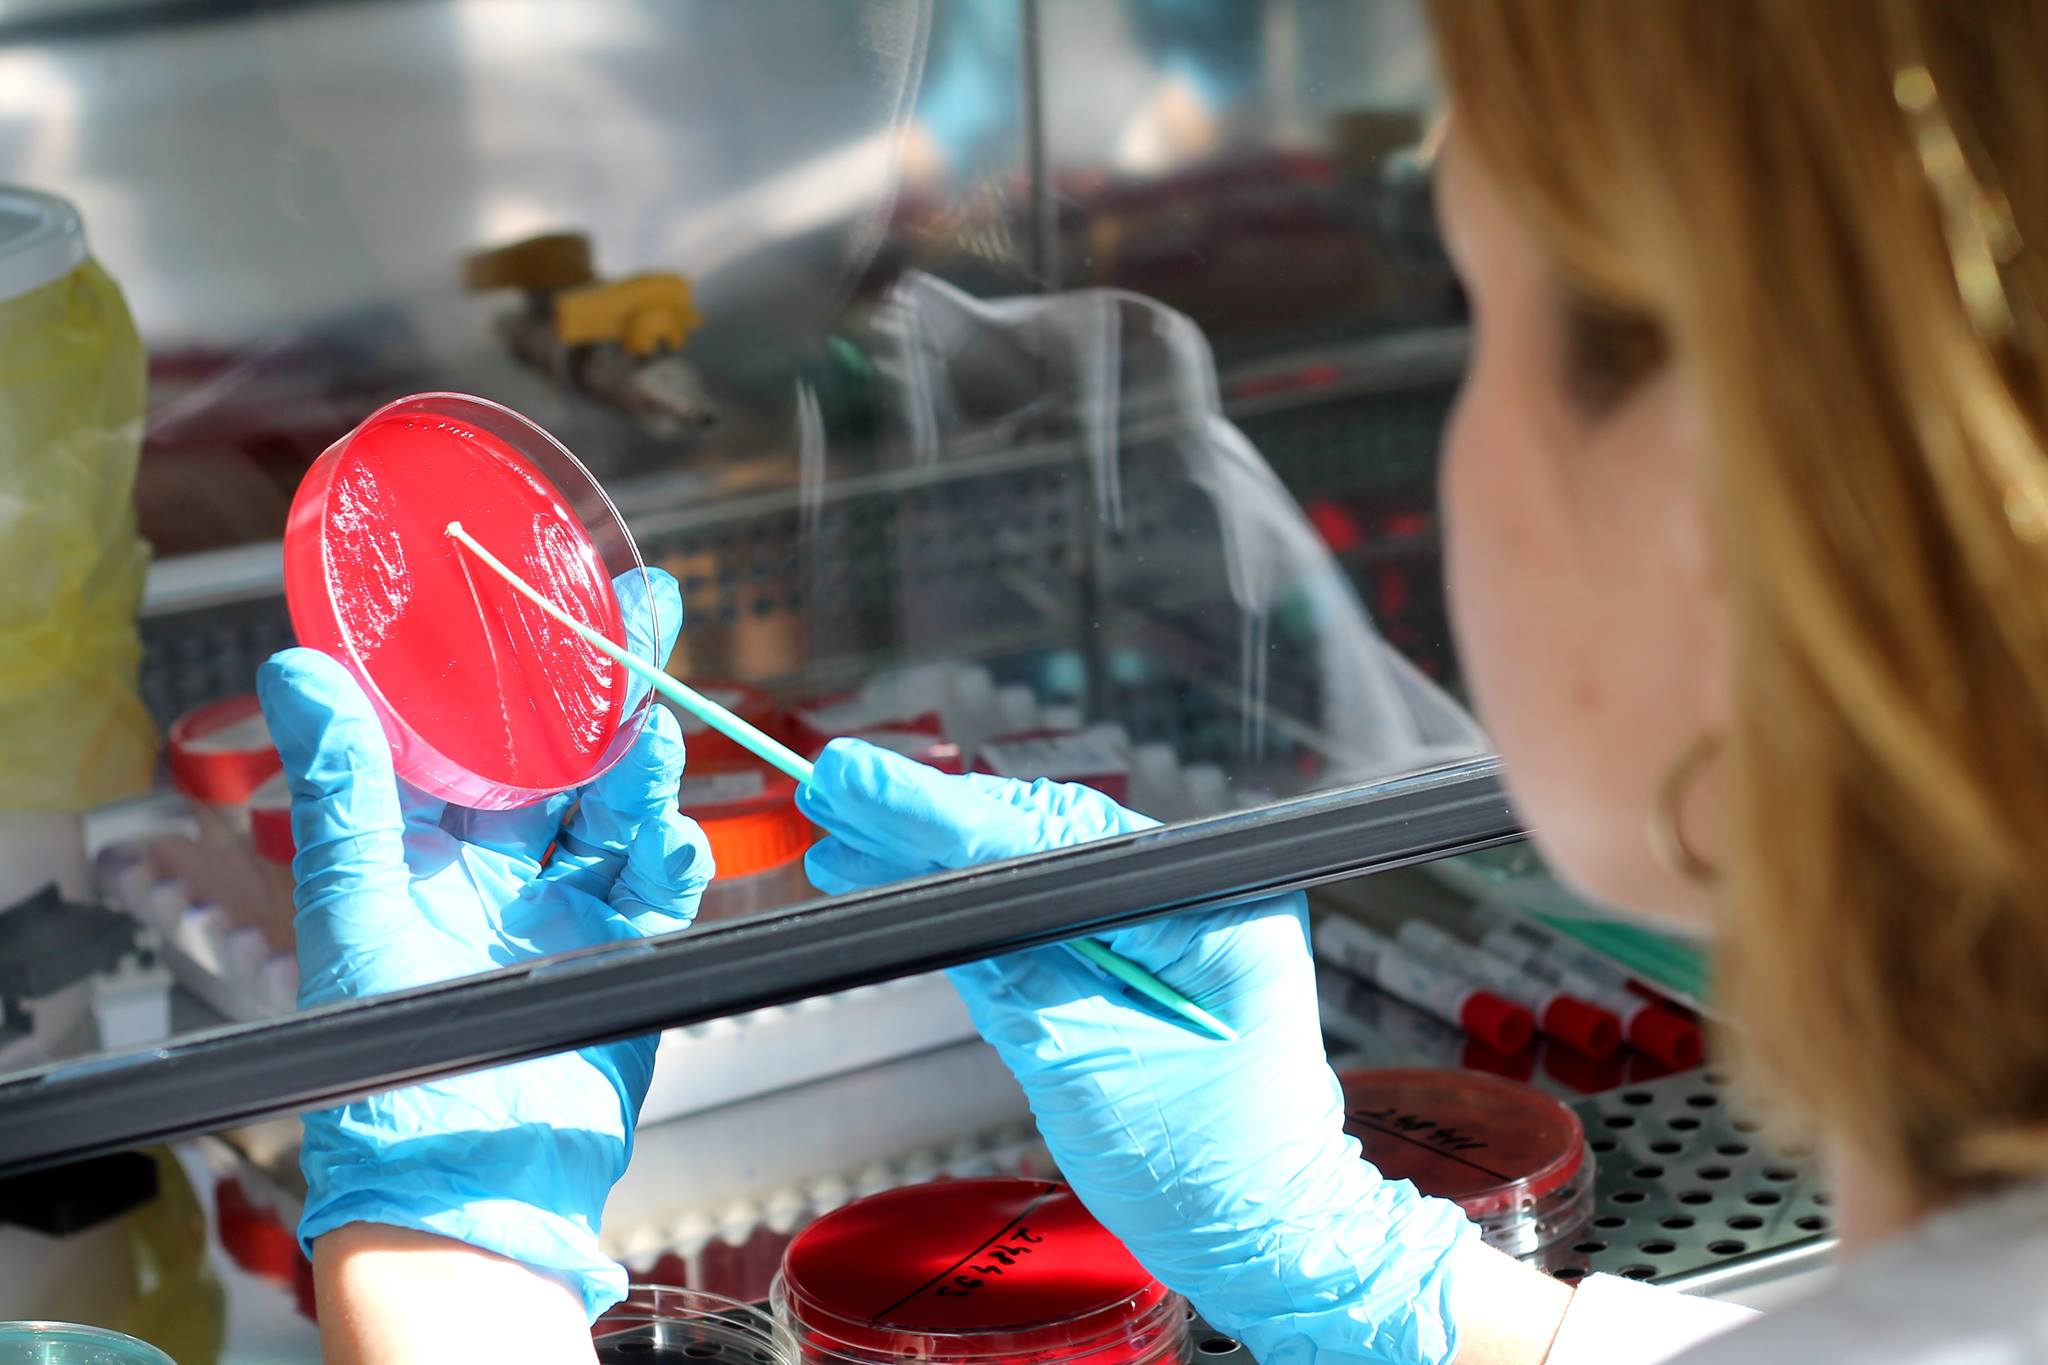

Nume: |
Analize Laborator Ecomed - Botosani |
E-mail: |
programari@ecomedbt.ro |
E-mail 2: |
ecomed@ecomedbt.ro |
Telefon: |
0737 021 297 |
Telefon 2: |
0231 529 788 |
Website: |
http://ecomedbt.ro/ |
Adresa: |
Botosani, Str. Piata Revolutiei, Nr. 11, Jud. Botosani. |
Laborator de analize medicale, centru de recoltare probe de sange / urina / materii fecale / secreţie vaginală/endocervicală, s.a., interpretare analize medicale: alergologie, biochimie, imunologie, hematologie, parazitologie, microbiologie, markeri cardiaci, endocrini, tumorali, virali, osoşi si pentru boli autoimune, serologie boli infectioase, teste de biologie moleculara, teste de citogenetica, toxicologie, histopatologie si analize decontate de CJAS.
Infiintata in anul 2002, in Dorohoi, compania ECOMED a pornit cu un singur laborator de analize medical si 3 angajati. Dupa doi ani, ECOMED vine aproape de pacientii din Botosani prin deschiderea Centrului Medical din Piata Revolutiei Nr. 11. Gama de servicii s-a marit, realizand atat analize medicale de laborator, cat si consultatii medicale de specialitate. Centrul medical Ecomed este structurat pe urmatoarele departamente: LABORATOR, CLINIC, IMAGISTICA MEDICALA, MEDICINA MUNCII, AVIZE MEDICALE, RECEPTIE, PROGRAMARI, INFORMATII si STERILIZARE SI BIOSECURITATE. Centrul Medical ECOMED tine pasul cu noile tehnologii, iar in 2010 se realizeaza in Botosani primul examen echografic 3D si 4D pentru depistarea si investigarea afectiunilor cardiace si obstetrice.
Laboratorul Centrului Medical Ecomed a devenit in 2004 primul laborator acreditat ISO din judetul Botosani si printre primele laboratoare acreditate din Romania, ca o recunoastere a calitatii deosebite a anlizelor de laborator. Ca urmare a cresterii permanente a numarului de afectiuni oncologice, in 2009 am dezvoltat compartimentul de imunologie, dotat cu un echipament aflat in varful tehnologiei de laborator, fiind primul si singurul de acest fel din judet. Realizam o gama de peste 130 de tipuri de analize medicale si dispunem de o retea de cabinete de specialitate, prin intermediul carora fiecare caz este tratat cu maximum de eficienta si seriozitate. Laboratorul nostru efectueaza analize medicale de hematologie, biochimie, imunologie, parazitologie si microbiologie de cea mai buna calitate cu aparatura si reactivi de ultima generatie, dispunand totodata si de cei mai buni specialisti.
Personalul laboratorului este format din medici, chimisti, biologi ai asistenti medicali cu indelungata experienta de laborator. Camerele de recoltare din centru sunt modern echipate pentru a asigura cele mai bune conditii de igiena, securitate biologica, precum si tot confortul pentru pacientii nostri. Prelucrarea datelor se face in sistem computerizat, prin intermediul unei aplicatii speciale de laborator, asigurându-se astfel centralizarea si validarea rezultatelor pentru emiterea buletinelor de analiza.
Centrul Medical Ecomed va ofera o gama complexa de servicii:
- Consultatii: neurologie, psihologie adulti, dermatologie, gastroenterologie, reumatologie, medicina interna, ginecologie, psihiatrie, pneumologie, endocrinologie, pediatrie, cardiologie, ORL, ginecologie, neurochirurgie;
- Analize de laborator: hematologie, biochimie, markeri tumorali, bacteriologie, imunologie, analize genetice prin laboratoarele partenere din tara;
- Explorari functionale: ecografie (generala, parti moi,articulatii, vase de sange, cardiaca, san, sarcina, ginecologica, tiroidiene), audiometrie, ECG;
- Eliberare avize medicale pentru eliberare/preschimbare permis de conducere, permis de port-arma, inscriere la diverse examene;
- Examinari medicale de medicina muncii cu eliberarea documentelor necesare angajarii sau pentru control medical periodic.
BOTOSANI – PIATA REVOLUTIEI NR. 11
PROGRAM:
LUNI - VINERI 07:00 – 17:00;
SAMBATA 08:00 – 13:00
PROGRAMARI:
Tel: 0231 529 788 / 0231 529 789
Mobil: 0737 021 297
Email: programari@ecomedbt.ro
BOTOSANI – CALEA NATIONALA NR. 95, ET. 2-3, CLADIREA BANCPOST
PROGRAM:
LUNI - VINERI 08:00 – 16:00
PROGRAMARI:
Tel: 0331 103 070
Mobil: 0737 021 299
Email: primaverii@ecomedbt.ro
DOROHOI – BULEVARDUL VICTORIEI, NR. 3-5, BL. A8
PROGRAM:
LUNI - VINERI 07:00 – 16:00
SAMBATA 08:00 – 15:00 CONFORM PROGRAMARILOR
PROGRAMARI:
Tel: 0231 615 202
Mobil: 0737 021 301
Email: dorohoi@ecomedbt.ro